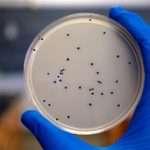
Симптоми та методи лікування стафілокока в мазку у жінок

Ляйсан Утяшева зворушливо привітала Павла Волю і показала рідкісні кадри з дітьми
33-річна Ляйсан Утяшева і її чоловік Павло Воля – одна з найбільш зразкових і щасливих сімей на нашому телебаченні. Закохані виховують двох дітей: сина Роберта та доньку Софію, разом подорожують по світу і радують Інтернет-користувачів сімейною ідилією на знімках.
Для маленьких мандрівників: 40 яскравих дитячих валіз
Діти — залучені учасники зборів в подорож. Здається, вони присутні відразу всюди: контролюють комплектацію аптечки, допомагають складати мамині сукні, приміряють татусеві шорти (а може, вже саме?!) і намагаються додати у валізу все нові і нові іграшки...
Марія Погребняк поділилася рецептами трьох ідеальних масок від мішків під очима
Чарівна багатодітна матуся і успішний дизайнер Марія Погребняк — активно веде свій особистий блог і регулярно балує численних фанатів цікавими кулінарними рецептами, порадами про красу і роздумами про виховання дітей.
Як запекти яблука в мікрохвильовці-4 різних рецепта на швидку руку
Для того щоб запекти яблука в свч з сиром, знадобляться: приготування: Запечене яблуко з сиром в мікрохвильовці готується просто і швидко. Для початку потрібно...
Відрижка блювотою … 38 тиждень
Вже 2-3 рази помічала що іноді буває відрижка як ніби блювотою🥺 днем голова на кілька секунд закрутилася... От не розумію що це, малятко іноді...
Тіматі подарував доньці цілу візок ляльок
35-річний Тіматі не тільки успішний артист, але і щасливий батько дівчинки Аліси. Малятко реперу подарувала його колишня кохана, Олена Шишкова (26). Батьки розлучилися, але зберегли дружні стосунки заради своєї спадкоємиці.Тіматі та Олена душі на чають в доньці і весь вільний час проводять з нею.
Старший син Юлії Барановської знявся в кліпі Діани Арбеніної
Телеведуча Юлія Барановська успішна не тільки в карєрі, але і у вихованні дітей, яких після розлучення з Андрієм Аршавіним вона виховує сама. Зірка присвячує весь вільний час 10-річної Яни, 6-річному Арсенію і 13-річному Артему.
Симптоми та методи лікування стафілокока в мазку у жінок
Зміст:Види збудникаСимптоми інфікуванняПричини появи стафілокока в мазкуДіагностичний мінімумМетодика лікуванняСтафілокок в мазку у жінок може виявитися абсолютно несподівано під час планового гінекологічного обстеження.
Ніжне рукостискання і сімейний флешмоб: Магоміси підкорили Суперкубок ❤️
Суперкубок 2025 року не тільки став аренкою для спортивних баталій, а й сценою зворушливої сімейної історії, яку розіграли Патрік і Бріттані Магомес зі своїми...
Чи можна нарощувати нігті під час вагітності?
Зміст: Думка лікарів Висновки Вагітна жінка передає більшу частину поживних речовин дитині. З-за цього її нігті стають крихкими і потребують додаткового догляду.
Дарина Мельникова: «Не відчувати відразу любові до своєї дитини – це нормально»
27-річна Дарина Мельникова зараз знаходиться у відпустці по догляду за дитиною. Нагадаємо, в грудні у зіркової пари Мельникова-Смольянінов народився другий син.
Кокон для новонародженого: чому він потрібен і який вибрати
Новонароджений спить більшу частину доби. І від того, наскільки комфортно облаштовано місце для сну, залежить його якість: часто дитина прокидається, здригається чи під час сну та інше.
Рідкісний кадр: Ігор Ніколаєв показав фото з хрестин доньки
Співак і композитор Ігор Ніколаєв — щасливий батько двох дочок: Юлії (40) від першого шлюбу зі шкільною любовю Оленою Кудряшевой і донечки Вероніки (3) від нинішньої дружини Юлії Проскуряковою.
Акушер розповіла, для чого проколює плодовий міхур в пологах
Породіллі завжди дуже вразливі і заздалегідь хвилюються, як б з дитиною, яка ось-ось зявиться на світ, нічого не сталося... Тому, коли під час пологів доктор говорить про необхідність прокол плодового міхура, починають хвилюватися.
Порада дня: искореняйте тривогу за допомогою казкотерапії
Як часто мами визнаються тривожності? Часто! Приводів для тривоги чимало. Наприклад:Ой, він впаде, пораниться. А якщо щось серйозне?Не підходь до голубів, вони розносять різні інфекції!Не гладь бездомну кішку, у неї може бути лишай!Кашляєш? Потрібно перевірити температуру...Від такої кількості потенційної небезпеки у мами йде обертом голова, а серце починає битися сильніше.
Як проявляється ентеробіоз у дітей і як його лікувати
Зміст:Ентеробіоз у дітей: загальна інформаціяПричини недугиПеребіг і наслідки паразитарної інфекціїСимптоми Що робити при виявленні ознак захворюванняЯк беруть зіскрібокЛікування паразитарної інвазії Прогноз і профілактикаЕнтеробіоз у дітей – захворювання кишечника, провоковане глистової інвазією.
Бронхопневмонія у дітей
Зміст:Різновиди захворюванняПричини Клінічні проявиУскладненняДіагностикаЛікування бронхопневмоніїБронхопневмонія у дітей – запальне захворювання легень, зачіпає стінки бронхіол і ділянки легеневої тканини.
Присмак гіркоти в роті у жінок
Зміст:Причини присмаку гіркоти в роті у жінокПро яких патологіях говорить гіркота у роті Лікування захворювань, що викликають гіркоту у ротіВідчуття присмаку гіркоти в роті у жінок може виникати раптово з різних причин.
Перша любов: 6-річний син Яни Рудковської розчулив Мережа фотосесією з дівчиною-моделлю
6-річний Сашко Плюшенко, син Яни Рудковської та Євгенія Плющенка, у своєму юному віці вже став по-справжньому популярною моделлю. Як не раз зізнавалася його зіркова мама, маленький Сашко цікавить дизайнерів по всьому світу, тому він стабільно бере участь у різних модних проектах.Вчора хлопчик знову провів час на фотозйомці.
Донька Олени Хмельницької вразила своїм малюнком
48-річна Альона Хмельницька не тільки популярна акторка, але і мама двох чудових дочок: Олександри (24) і Ксенія (8). Дівчатка народилися в шлюбі з відомим кінорежисером Тіграном Кеосаяном.© Instagram @alxmelНезважаючи на розлучення, знаменитості зуміли зберегти прекрасні відносини.